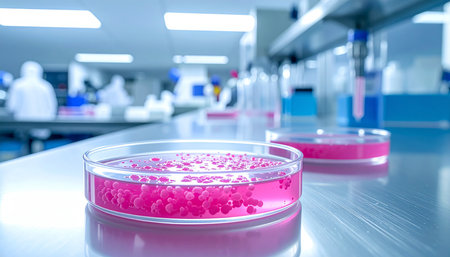
Pink bacterial colonies are visible in a petri dish on a metal surface in a laboratory.の素材

素材 - Pink bacterial colonies are visible in a petri dish on a metal surface in a laboratory.
作品情報
Pink bacterial colonies are visible in a petri dish on a metal surface in a laboratory.
- ID:262813710
- 作品種別:
- 作者名:afdgfghfgyhfg
キーワード
- analysis
- bacteria
- biology
- biotechnology
- cleanroom
- close-up
- colonies
- culture
- detail
- equipment
- experiment
- flask
- fluorescent lights
- growth
- healthcare
- laboratory
- macro
- medical
- metal surface
- microbiology
- microscope
- petri dish
- pharmaceutical
- pink
- research
- sample
- science
- scientific
- scientist
- sterile
- technician
- test tube
類似作品
Bacteria of dif...
Green cactus on...
macro photograp...
purple colored ...
bacteria colony...
Water bubbles o...
Bacterias under...
Gel fluid splas...
Cosmetic swatch...
Strawberry Ice ...
Pink vibrator u...
E. coli.
texture of a st...
Colored stem ce...
Bacterial colon...
Handmade mucus ...
Colorful backgr...
Eggs of a Taeni...
multicolor wate...
Probiotic bacte...
Eggs of a Taeni...
Colorful pills ...
watercolor back...
Abstract red wa...
close-up water ...
pink foam textu...
purple colored ...
Background red ...
A close up of a...
Still life with...
High-definition...
Bacterial colon...
Colony of bacte...
shifting forms ...
Texture of wate...
A stunning micr...
Colorful bubbly...
3d rendered med...
microbiology la...
Pink foam of a ...
Drops of gel on...
Abstract macro ...
shapes of keys ...
Bath bomb disso...
Abstract backgr...
An exquisite cl...
Black and pink ...